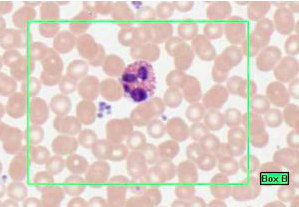
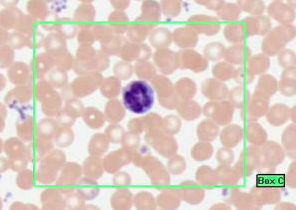
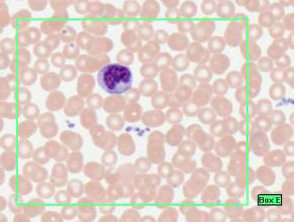
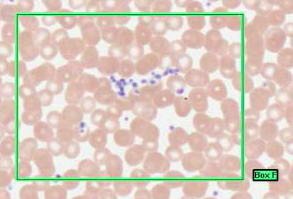

What does Alican blue stain blue? (4)

GAG (glycoaminoglycans)
Mast cells
Cartilage
Mucus
GMCM

What does eosin stain? (2)

Plasma and colloid proteins
Eosinophilic = acidophilic
What does Iron heamatoxylin stain black? (2)

Iron heamatoxylin stains…
Nuclei & elastic fibres black
What does periodic acid sniff stain magenta?
HCGGBB
Hexose sugars (complex carbs)
Catrilage matrix
Glucose
Goblet cell mucins
Brush border enzymes
Basement membranes
Where is cilia found?

The airways (nose, larynx & bronchial tree)
The fallopian tube
What are the 2 contractile proteins involved in cillary movement?
Tubulin and dyneine
Which cells are the dark & dense nuclei here from?

This is nerve cell bodies.
The small, dense and dark nuclei are from satellite cells
Where is the NISSL substance on this slide?
What does NISSL substance do?

NISSL substance = the dark staining patches in the perikaryon (cyt around the nucleus)
NISSL = rER - synthesis of proteins
(this is from sensory cell bodies from the DRG - Sensory are more rounded than motor)
What are the roles of eosinophils?
Phagacytose antigen/antibody complex
Parasitic infections
Neutralise histamine
What is the role of basophils?
Are basophils more/less common than eosinophils?
Basophils
What happens after this cell arives at the site of infection?
Monocyte (kidney shaped nucleus)
Arrive after neutrophils in an acute inflammation - differentiate into macrophages
What granules do these contain?
These are platelets -
Alpha granules = clotting factors
Dense granules
Lysosomes
Perioxosomes = elimination of oxygen radicals